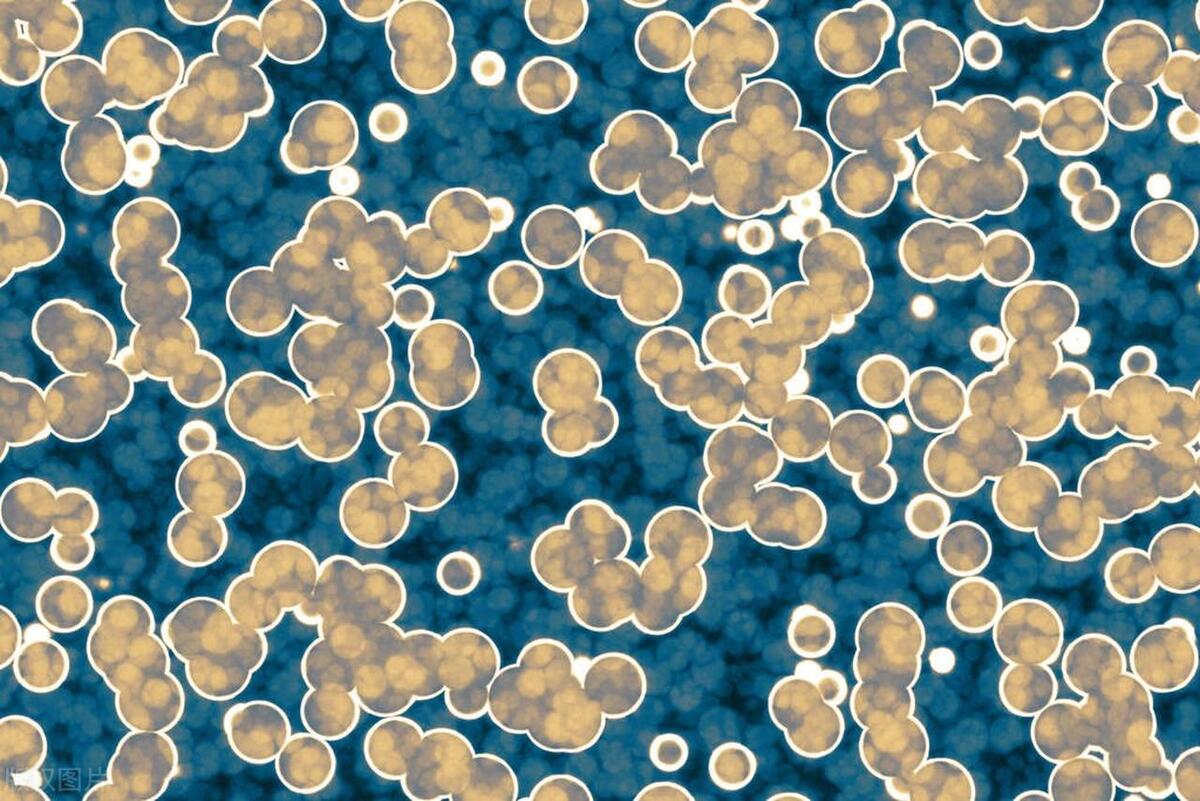
阿莫西林跟头孢是抗生素吗,阿莫西林和头孢哪一种消炎好

所谓的炎症,就是当身体受伤时,身体的免疫系统会自发地对受伤的地方进行修复。然后出现 发红,发肿,发热,疼痛 等症状。
一般来说大部分的炎症都是可以自己消失的,但是也有一部分是必须要依靠药物来缓解的,这时候就需要用到 消炎药 了。

与细菌感染无关的骨性关节炎、类风湿性关节炎、痛风等疾病,主要是使用 非甾体类消炎药 和 类固醇类消炎药 ,能够直接抑制炎症,缓解或停止炎症反应。

第二种是 抗生素药物 ,比如 青霉素、头孢、左氧氟沙星 等,主要作用是杀死细菌,从根源上解决问题,从而达到缓解炎症的作用,主要适用于由细菌感染导致的中耳炎、扁桃体发炎等。
一般情况下,如果是因为细菌感染导致的炎症,可以考虑使用抗生素进行消毒,从而间接的消炎。但最终的目标是消毒。
今天我们要说的,就是 阿莫西林和头孢 ,这是一种抗菌素。阿莫西林与青霉素相比,对其结构进行了一定程度的调整,使其具有较强的抗酸能力,因此更适宜于口服给药。

在现实生活中,有不少人将阿莫西林和头孢视为“万能神药”,一有炎性反应,立刻服用。
但他们并不知道,这种药物并不是单纯的抗炎药物,阿莫西林和头孢并非抗炎灵丹妙药,服用之后,会对身体造成伤害!
一、 阿莫西林
1、 阿莫西林滥用后果严重

阿莫西林是一种抗菌药,能够用来治疗粪肠球菌、肺炎链球菌、幽门螺杆菌、溶血性链球菌等细菌性感染疾病。
至于消炎药,就是一种可以抑制人体之中“非感染性”的发炎反应的药物,主要是针对人体内由于发炎而出现的酸痛、红肿等症状,其中最常见的两种,一种是 布洛芬 ,一种是 阿司匹林 。

2、 消炎药跟阿莫西林等抗生素是两种不同的东西
目前,在临床上,九成以上的感冒都是由于病毒感染所致,而不能确定是否为细菌所致,这样的话,即使是阿莫西林这样的抗菌药物也起不到什么作用。
况且,即使是细菌性的感染,若是没有正确的用药,也会造成菌群失衡,引发继发性感染,加重病情。
但,更惨的还在后面。
- 产生抗药性
在抗生素被滥用之后,少数具有抗药性的超级细菌会变成病原菌的主要力量,导致本来有效的抗生素效果下降,甚至失去作用。
这个时候,超级细菌仍然可以在人体内传播,但是被感染的人却因为对抗生素产生了抗药性,从而导致了无法治愈的困境。
- 出现副作用
抗生素的滥用会造成人体内的菌群失衡,同时也会增加药物的毒副作用,会对肝肾、造血系统、肠胃系统、神经系统等造成损害,例如:链霉素的滥用,会造成恶心、呕吐、耳鸣、头疼、耳聋等症状。

- 延误病情
一有疾病就使用抗生素,很容易造成一种“我已经好了”的错觉,增加了确诊的难度,从而也让病人错失了最好的治疗机会。

3、 阿莫西林只对一定病情起作用
阿莫西林是一种半合成的青霉素,它有很强的抗菌和穿透力,但并不是所有的细菌都能起到很好的效果,通常情况下,它只对下列六种细菌有效况,所以大家要对症下药,不能盲目使用。
- 下呼吸道感染
一般因外界各类病原菌通过呼吸道感染引起,如由溶血链球菌、肺炎链球菌、葡萄球菌或流感嗜血杆菌所致 中耳炎、鼻窦炎、咽炎、扁桃体炎 等,此时用阿莫西林抗菌可起到较好效果。

阿莫西林是一种抗菌药物,主要用于治疗肺炎、急性支气管炎等,主要是在呼吸道感染的情况下使用。
- 消化道感染
幽门螺杆菌 (H.py lo ri)是导致胃癌发生的重要原因之一,阿莫西林(Aimoxins)是一种有效的抗幽门螺杆菌药物,临床资料显示其治疗效果可达到85%以上。

另外,阿莫西林对肠道细菌引起的轻度、中度感染也有一定的疗效。
- 皮肤软组织感染
有可能是由于外界因素造成的,还可能是身体免疫力下降造成的,所以可以选用阿莫西林这种药来缓解。

- 泌尿生殖道感染
阿莫西林还可用于治疗由大肠杆菌和克雷伯杆菌属引起的 泌尿系统感染性疾病 ,如由大肠埃希菌引起的炎症和细菌感染。

- 急性单纯性淋病
急性单纯性淋病 是由淋球菌感染所致,阿莫西林可以在一定程度上杀死淋球菌,从而达到消退炎症、减轻症状的目的。
综上虽然都是杀菌剂,但每一种杀菌剂,都有它的优势,也有它的优势。

对于 急性支气管炎 患者,阿莫西林是有效的,但是对于由大肠杆菌引起的肠道炎症,阿莫西林的效果并不明显。因此,即使确诊为细菌性疾病,是否服用阿莫西林,也要因人而异。
4、 服用禁忌,以防良药变毒药
在感染的时候,适当的使用抗生素可以起到一定的作用,但是“是药三分毒”,如果服用不当,不仅起不到有效的治疗作用,还会对身体造成伤害。

尤其是使用像阿莫西林之类的抗菌药物时,更应该注意下列事项:
- 不能和这些药物同服
在服用阿莫西林期间,一定要注意避免同时服用生物制剂、抗凝血药物、避孕药、丙磺舒等药物。
益生菌等生物制剂 :阿莫西林为杀菌药物同服会导致菌群失活。
抗凝血药物 :同服会延能血政原时间 导致患考出现抗凝水平异常。

避孕药 :与阿莫西林一起吃会刺激雌激索代重或减少其肠-肝循环 降低口避孕效果。
丙磺舒 :两种药物同时服用会导致阿莫西林血浓度升高,对器官造成刺激。

- 不能和这些食物同服
首先,尽量不和这些食品一起吃,例如: 菠菜,花菜,胡萝卜 等,假如阿莫西林被粗纤维所吸收,它的浓度会降低,从而药效会减弱。
其次,不能吃 辛辣刺激,生冷,油腻 的东西。

如果多吃的话,很有可能会对肠胃功能造成很大的伤害,也有可能会对阿莫西林的药效产生影响,甚至有可能造成过敏反应。
阿莫西林是一种抗菌素,如果和 酒精 一起服用,会引起双硫伦反应,症状稍微轻一点,会引起皮肤红肿,严重的话会引起呼吸困难,更加严重的话还会因为 休克而死亡 。

- 温水送服
阿莫西林在受热时会形成致敏物质,容易引起患者的过敏反应,所以服用时最好选择 60 摄氏度以下的 温开水 或者是 凉开水 。

5、 服用阿莫西林要注意
阿莫西林的不良反应比较少,对肝脏和肾脏均有轻度损伤,但需要注意以下三个方面:
- 对于有 青霉素过敏史 的患者, 禁止使用阿莫西林 ,以免导致过敏性疾病,严重时会导致肾衰;
- 如果不能在没有适应症的前提下服用阿莫西林,很可能会出现 抗药性 ,而抗药性一旦出现,在阿莫西林的实际应用中,就不能起到应有的效果;

- 阿莫西林 长期服用 ,极易出现 继发感染 。
一般情况下,体内的微生物处于一个相对稳定的状态,但长期服用阿莫西林,会让体内的微生物受到压制,导致体内的微生物失衡。
从而导致对阿莫西林有抵抗力的微生物,开始疯狂地繁殖,形成二次感染。

二、 头孢
1、 阿莫西林和头孢有很大的不同
在临床治疗中, 头孢 属于最常见的一种抗生素类型,世界上首个头孢菌素是在20世纪60年代出现的,到现在已经有60多个种类的上市品种。
头孢与阿莫西林的不同,就像是青霉素与头孢类抗生素的不同。

- 目的不同
如果是 细菌感染 ,可以在初期使用青霉素,所以阿莫西林是比较适合在初期使用的。
如果出现了青霉素的耐药菌株,说明青霉素无效,可以考虑使用头孢类抗生素,这是一种阶梯治疗。严重的感染可以使用头孢类的药物。
- 不同的安全措施
青霉素 是比较容易引起过敏症的一种,头孢类抗生素是比较安全的一种。
头孢一代、二代是有肾毒性的,但是现在已经开发出了四代的头孢抗生素,它的抗菌谱很广,对感染的治疗也很有效。

- 分类不同
阿莫西林是一种特殊的、单一的药物,而头孢是一种药物,它的种类相对较多,属于一个很大的家族。
2、 头孢适用病情
头孢拉定胶囊、头孢克肟胶囊、头孢克洛分散片等可用于呼吸道感染、泌尿系统感染、皮肤感染等,也可用于治疗。
- 呼吸道感染 :呼吸道感染一般与细菌、真菌等病原菌感染有关,可口服头孢消炎药进行消炎杀菌。
- 泌尿系统感染 :泌尿系统感染,也有可能是因为细菌感染引起的,可以在医生指导下口服头孢消炎药进行治疗。

- 皮肤感染 :皮肤感染,一般都是因为炎症刺激引起的,可以通过口服头孢类抗生素来进行抗感染。
3、 注意事项
除了上述的情况,还可以口服一些头孢类的消炎药,如胃肠道感染等。
当出现咽痛、咳嗽等症状时,如果出现血象偏高的症状,可能会出现细菌感染的症状。
得了感冒之后,要以清淡的饮食为主,多吃一些 蔬菜水果 ,多喝一些水。
在服用头孢的过程中,由于头孢与酒精会产生双硫仑反应,所以需要在医生的指导下及时服药。
参考资料:
[1]《头孢和阿莫西林有什么区别》.饮食保健. 2019-09
[2]《抗生素危害的研究进展》.现代养生. 2017-04
[3]《滥用抗生素危害大》.中华养生保健. 2012-09-01
[4]《如何正确使用抗生素》.药物与人. 2009-08